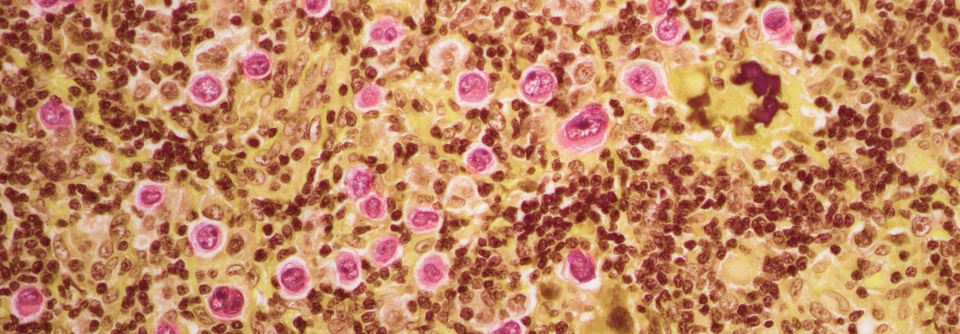

Im Rahmen unserer Website-Modernisierung arbeiten wir kontinuierlich daran, Ihnen noch bessere und aktuellere Informationen zu bieten. Diese Seite wird in Kürze mit frischen Inhalten und einem zeitgemäßen Design überarbeitet.
Hepatitis C
Erreger der Hepatitis C ist das Hepatitis-C-Virus (HCV), das 1989 erstmals identifiziert wurde (vorher Hepatitis Non-A-non-B).
Das RNA-Virus aus der Familie der Flaviviren weist eine hohe Mutationsrate und genetische Variabilität auf. Es gibt 6 Genotypen mit mehreren Subtypen. In Deutschland findet man am häufigsten den Genotyp GT 1 (78%), gefolgt von GT 2/3 (18%) GT 4 (3%) und GT 5/6 (1%) .
Etwa 1% der Weltbevölkerung sind chronisch mit HCV infiziert. In Deutschland liegt die Prävalenz bei 0,3%, im Mittelmeerraum bei 2-3% und in einigen Ländern Afrikas bis zu 15%. Etwa 30% aller Fälle von Leberzirrhose und 25 % der Leberzellkarzinome sind durch HCV-Infektionen bedingt.
Gesichert ist eine Übertragung von HCV auf parenteralem Weg durch Kontakt mit kontaminiertem Blut z. B. bei i.v.-Drogengebrauchern, unsterilem Peircing und Tätowieren und Empfängern von Blutprodukten (seit Einführung der Testung 1991 in Deutschland kaum noch relevant). Eine Übertragung durch Sexualkontakte ist im Prinzip möglich, scheint jedoch keine große Rolle zu spielen (mit Ausnahme von HIV-positiven homosexuellen Männern). Nach Nadelstichverletzungen mit HCV-haltigem Blut liegt das Risiko bei etwa 1%. Auch eine Übertragung von der virämischen Mutter auf das Kind ist möglich – das Risiko liegt bei etwa 5 %.
Im Serum einer infizierten Person kann HCV-RNA bereits wenige Tage nach Infektion messbar sein. Die Serokonversionszeit beläuft sich auf 2 Wochen bis 6 Monate (in der Regel werden Antikörper 7 bis 8 Wochen nach Infektion messbar).
Etwa 60-85% der HCV-Infektionen gehen in eine chronische Form über (definiert als länger als 6 Monate fortbestehende Infektion mit HCV). Circa 16-20% der Personen mit chronischer Hepatitis C entwickeln nach 20 Jahren als Spätfolge eine Zirrhose mit zunehmendem Funktionsverlust der Leber – nach 30 Jahren wird der Anteil auf 41 % geschätzt. Diese Patienten haben dann ein hohes Risiko für ein Leberzellkarzinom (jährlich 2-4 %, bei Alkoholkonsum ist das Risiko höher).
Bei etwa 75% der Betroffenen verläuft die akute Infektion ohne auffällige klinische Symptomatik oder führt nur zu unspezifischen, grippeähnlichen Symptomen. Die Infektionen verlaufen dann meist chronisch.
Etwa 25% der Infizierten entwickeln eine meist milde ausgeprägte Hepatitis mit oft nur mäßig erhöhten Transaminasenwerten und Ikterus. Bei diesen Patienten kommt es in 50% zu einer spontanen Ausheilung.
Auch die chronische Form verläuft meist mild mit unspezifischen Symptomen wie
- Müdigkeit
- Unspezifische Oberbauchbeschwerden
- Leistungsminderung
- z.T. Juckreiz und Gelenkbeschwerden
Zusätzlich können bei chronischer Hepatitis C extrahepatische Komplikationen auftreten wie z.B.:
- Kryoglobulinämie
- Glomerulonephritis
- Diabetes mellitus
- Hashimoto-Thyreoiditis
- Sjögren-Syndrom
Der Untersuchungsbefund bei Hepatitis C ist meist unspezifisch. Bei einem Viertel der Patienten mit akuter Hepatitis findet man einen Ikterus.
Als Screeningtest bei Risikopersonen wird eine Bestimmung von Antikörpern (anti-HCV) empfohlen. Die Antikörper werden aber erst 1-5 Monate nach Infektion positiv, sodass hier eine diagnostische Lücke entsteht.
Bei positivem anti-HCV-Nachweis muss dann immer zum Nachweis der Virämie quantitativ HCV-RNA mittels PCR bestimmt werden. Ist HCV-RNA trotz poisitver Antikörper nicht nachweisbar, kann man von einer ausgeheilten Infektion ausgehen.
Vor Einleitung einer antiviralen Kombinationsbehandlung soll der HCV-Genotyp sowie bei Genotyp-1-Isolaten zusätzlich der Subtyp (1a oder 1b) bestimmt werden. Dies ist wichtig für die Abschätzung der Prognose und die Auswahl der antiviralen Substanzen.
Weitere Laboruntersuchungen:
- Transaminasen (Normalwerte schließen chronische Hepatitis C nicht aus)
- γ-GT, alkalische Phosphatase
- großes Blutbild
- Kreatinin und Harnstoff
Weitere Untersuchungen:
Sonographie, Fibroscan oder evtl. Leberbiopsie zur Bestimmung des Fibrosegrades
Da sich die Symptomatik der Infektionen durch die verschiedenen Hepatitisvirusarten grundsätzlich nicht unterscheidet, muss auch an Hepatitis A, B und E gedacht werden. werden.
Weitere Differenzialdiagnosen:
- Infektionen mit Epstein-Barr-Virus, humanen Zytomegalieviren sowie (bei Immundefizienten) mit Herpes-simplex-Viren und Varizella-Zoster-Virus
- bakterielle Infektionen (z.B. Brucellose, Q-Fieber, Leptospirose oder Echinokokkose)
- bei Reisen in tropische Länder auch Viral-Hämorrhagisches-Fieber, Malaria und Amöben-Infektion
- toxische Hepatitis (z.B. durch Alkohol oder Medikamente)
- Autoimmunhepatitis
Akute Hepatitis C
Die akute symptomatische Hepatitis C stellt in der Regel aufgrund der 50%igen Chance auf eine spontane Ausheilung keine Indikation für eine antivirale Therapie dar. Es gibt aber Ausnahmen wie:
- Nadelstichverletzungen
- ausgeprägte Symptomatik
- Komorbiditäten
- extrahepatische Manifstationen
Behandelt werden kann dann mit der Kombination Ledipasvir/Sofosbuvir für 6-8 Wochen – der Einsatz von Interferonen wird hier nicht mehr empfohlen.
Chronische Hepatitis C
Eine chronische Hepatitis C stellt immer einen Indikation für eine antivirale Kombinationstherapie dar. Erhöhte Transaminasen oder Nachweis einer Fibrose sind dabei keine notwendigen Voraussetzungen.
Empfohlen werden heute als Ersttherapie immer ein interferonfreies Therapieregime. Zur Verfügung – z.T. nur in Form von Fixkombinationen –stehen:
Ribavirin
- in Kombination mit anderen Substanzen zur Erst- und Re-Therapie bei allen Genotypen zugelassen
Direkte antivirale Substanzen (DAA):
NS3/A4-Proteaseinhibitoren:
- Glecaprevir (GPR) → HCV-Genotypen 1-6
- Grazoprevir (GZR) → HCV-Genotypen 1-4
- Voxilaprevir (VOX) → HCV-Genotypen 1-6
- Paritaprevir (PTV) → HCV-Genotypen 1-4
Simeprevir, Bocprevir und Telaprevir sind in Deutschland nicht mehr erhältlich.
NS5A-Inhibitoren
- Daclatasvir (DCV) → Genotypen 1-6 (wird in Deutschland aus wirtschaftlichen Gründen nicht mehr eingesetzt)
- Elbasvir (EBR) → Genotypen 1 und 4
- Ledipasvir (LDV) → Genotypen 1,4,5,6
- Ombitasvir (OBV) → Genotypen 1 und 4
- Pibrentasvir (PBR) → Genotypen 1-6
- Velpatasvir (VEL) → Genotypen 1-6
Nukleosidische Polymerase (NS5B)-Inhibitoren
- Sofosbuvir (SOF) → Genotypen 1-6
Die Substanzkombination und die Therapiedauer (8 oder 12 Wochen) hängen von zahlreichen Faktoren wie Genotyp, Zirrhosesstatus, antiviralen Vortherapien und viralen Resistenzen ab. Nach Therapieende (nach 12 Wochen) sollte eine Erfolgskontrolle mittels qantitiativer Bestimmung der HCV-RNA erfolgen.
Meldepflicht:
Dem Gesundheitsamt müssen der Krankheitsverdacht, die Erkrankung sowie der Tod an akuter Virushepatitis sowie alle Nachweise von Hepatitis-C-Virus namentlich gemeldet werden.
Bei fortgeschrittener dekompensierter Leberzirrhose kann nach den allgemeingültigen Kriterien eine Lebertransplantation indiziert sein.
Eine wirksame Schutzimpfung gegen HCV steht bisher nicht zur Verfügung und auch eine früher durchgemachte HCV-Infektion schützt nicht vor einer erneuten Erkrankung.
Daher bleibt nur eine Expositionsprophylaxe, z.B. durch:
- strengste Überprüfung von Blut und Blutproduktenspenden
- Schutzmaßnahmen bei möglichen Blutkontakten (Handschuhe, Gesichtsmaske, Schutzbrille)
- Aufklärung von i.v.-Drogengebrauchern
Deutsche Gesellschaft für Gastroenterologie, Verdauungs- und Stoffwechselkrankheiten (DGVS):
Therapie der chronischen Hepatitis C
S3-Leitlinie
Prophylaxe, Diagnostik und Therapie der Hepatitis-C-Virus (HCV) -Infektion
Verschenken Sie kein Honorar: Das „Gebühren-Handbuch digital“ ist die ideale Weiterentwicklung der Printausgabe des bekannten „Medical Tribune Gebühren-Handbuchs“ - statt 2000 Buchseiten der schnelle digitale Zugriff.
Was Ihnen die Abrechnung leichter macht:
- die immer aktuelle Fassung von EBM und GOÄ (Einheitlicher Bewertungsmaßstab und Gebührenordnung für Ärzte)
- Tipps und Experten-Kommentare zur Honorarabrechnung (EBM/GOÄ), graphisch aufbereitet und leicht verständlich
- Kommentare von Kollegen lesen und selbst kommentieren
- persönliche Notizen und Lesezeichen setzen
Fortbildungen
Keine Fortbildung für diesen Fachbereich gefunden
Alle FortbildungenDiese Informationen dienen ausschließlich der Aus- und Weiterbildung von Angehörigen und Studenten der medizinischen Fachkreise (z.B. Ärzte) und enthalten nur allgemeine Hinweise. Sie dürfen nicht zur Selbstdiagnose oder -behandlung verwendet werden und sind kein Ersatz für eine ärztliche Beratung oder Behandlung. Die jeweiligen Autoren haben die Inhalte nach bestem Wissen gepflegt. Dennoch sollten Sie die Informationen stets kritisch prüfen und mit zusätzlichen Quellen vergleichen. Die Autoren und die Betreiber von medical-tribune.de übernehmen keine Haftung für Schäden, die durch nicht-kontrollierte Anwendung von Empfehlungen und Inhalten entstehen. Beiträge, die Angaben zum Einsatz und zur Dosierung von Medikamenten machen, sind die persönliche Einschätzung der Autoren. Sie ersetzen nicht die Empfehlungen des Herstellers oder des behandelnden Arztes oder Apothekers.